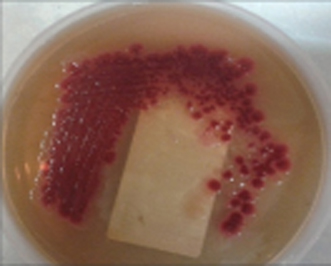

Infections are one of the leading causes of morbidity and mortality in our country. Apart from
the common bacterial and viral infections; tropical infections like malaria, dengue, diarrhea, tuberculosis
etc. are our major concerns. The whole world, including India, is facing an epidemic of the deadly disease
HIV. The number of hospital acquired infections is also on the rise. Opportunistic fungal infections like
candidiasis, aspergillosis, mucormycosis are no longer rare infections due to the growing population of
immunocompromized patients.
After years of practicing at leading hospitals in India, Dr. Surabhi Madan now has her own Infectious Diseases
Clinic in Ahmedabad called Tathaagat, from where she will be serving patients from any part of the world.

Infection of bone (osteomyelitis) can occur spontaneously or can be secondary to some injury/trauma or
surgery.

A. Chronic backache, progressively increasing, not responding to pain killers may be due to infections
like Tuberculosis and Brucella.
Infective endocarditis is the infection of the endocardialsurface (the innermost surface)of the heart.

Acute gastro-intestinal infections are most commonly viral and present with diarrhoea, vomiting,
abdominal pain, fever of short duration.

These are infections affecting the genital organs- eg. vaginitis, cervicitis in females and
epididymo-orchitis (infection of the testis) in males.

Pneumonia is the infection of the lungs, acquired by inhaling the infecting particles/organisms.

Infectious Diseases Specialist
MD, General Medicine, Fellowship in Infectious Diseases
Dr Surabhi Madan is one of the few certified doctors in India who are qualified in the field of Infectious
diseases. She has been trained in Infectious diseases at thePD Hinduja National Hospital and Research Centre,
Mumbai; a highly renowned and prestigious medical institute of the country. Presently she is pursuing her
career as an Infectious Diseases consultant in Ahmedabad, Gujarat.
Dr Surabhi Madan passed her MBBS and MD in General Medicine from Government Medical College Surat, Gujarat.
She stood as the first ranker and a gold medalist in the university.